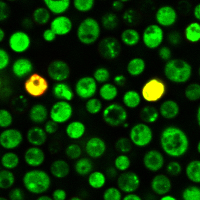
Yeast Live-or-Dye™ Fixable Live/Dead Staining Kit - Image 3

Yeast Live-or-Dye™ Fixable Live/Dead Staining Kit
A fixable, fluorescent assay to determine yeast viability. Contains two fluorescent components, Thiazole Orange and Live-or-Dye™ 568/583.
Please fill in the inquiry form and we will contact you shortly.
Wishlist updated! View wishlist
Product Description
The Yeast Live-or-Dye™ Fixable Live/Dead Staining Kit is a fixable, fluorescent assay to determine yeast viability. The kit contains two fluorescent components, Thiazole Orange and Live-or-Dye™ 568/583.
The kit has been validated in the following species: Saccharomyces cerevisiae, Candida albicans, Aspergillus niger, and Zygosaccharomyces bailii.
Features
- Stable and selective dead cell staining
- Simple, rapid, no-wash staining protocol
- Tolerates formaldehyde fixation
- Suitable for flow cytometry and microscopy
Kit Components
- Live-or-Dye™ 568/583 (solid), 4 vials
- Thiazole Orange 10 mM in DMSO, 100 uL
- Anhydrous DMSO, 250 uL
Spectral Properties
- Live-or-Dye™ 568/583 Ex/Em 568/583 nm
- Thiazole Orange Ex/Em 512/533 nm
How It Works
Live-or-Dye™ 568/583 is a cell membrane impermeable amine-reactive dye. It is able to enter into dead cells that have compromised membrane integrity and covalently label free amines on intracellular proteins. This dye labeling is extremely stable, allowing the cells to be fixed and permeabilized without loss of fluorescence or dye transfer between cells. It is suitable for detection by fluorescence microscopy or flow cytometry.
Thiazole Orange is a green fluorescent dye that localizes to the cytoplasm, with some nuclear accumulation. It is fixable, resulting in diffuse cytoplasmic staining in fixed cells.
After staining yeast with this kit, both living and dead cells will be stained with green fluorescence. Only dead cells will be stained with red fluorescence.



References
ACS Appl. Bio Mater. (2020) doi: 10.1021/acsabm.0c00985